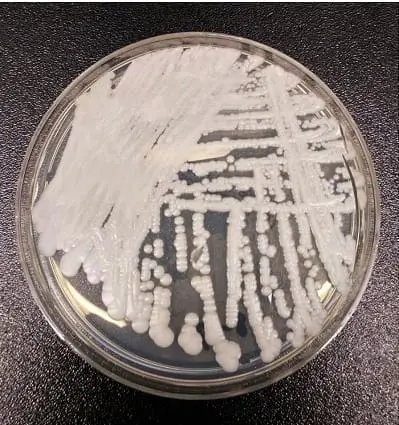
カンジダ・オーリス：弱った免疫系への新たな脅威

洪水後のカビの警告サイン
ハリケーンや激しい雷雨の発生率が高まるにつれ、洪水の脅威も増している。 残念なことに、洪水による水や瓦礫が取り除かれた後は、カビという別の危険が進行していることが多い。 カビの胞子はその小さなサイズにもかかわらず、吸い込んだり食べたりすると人体に大惨事をもたらす。 自宅の洪水に対処することは十分な外傷ですが、本格的なカビの蔓延は長期的な問題を引き起こす可能性があります! アウトブレイクとの闘い 一般的に、カビが表面に発生するには24時間から48時間かかると言われている。 したがって、洪水が発生した後は、大きな問題を防ぐために迅速に行動することが絶対に重要である。 カビを寄せ付けないためのヒントをいくつか紹介しよう: サンシャイン・イン (1)外が雨でないこと、(2)乾燥させようとしている空間の相対湿度が外の相対湿度より高いこと。 可能であれば、少なくとも数日間は、日中はドアや窓を開けたままにし、夜間は閉めておく。 大砲を持ち出す 小さな水たまりを拭き取るには数枚のタオルで十分かもしれないが、洪水にはもっと高度な道具が必要だ。 扇風機、水ポンプ、ウェット・ドライ・バキュームなどを使って、できる限り表面から湿気を取り除く。 そして、水分の大半が取り除かれた後は、除湿機が残った水分を取り除くのに役立つ。 濡れたものを取り除く 箱、家具、「後で何とかする」と自分に言い聞かせながら地下室に放り込んだ残り物、その他諸々……! 屋外に保管するのが理想的だが、十分な換気があればガレージでも構わない。 このアイデアは、水浸しの環境にこれ以上さらされることなく、これらの品物を乾燥できるスペースに運ぶことだ。 クリーニング 金属、ガラス、プラスチックのような素材でできた、硬くて無孔質のものは、たいてい洗浄できる。 カビや白カビ専用の市販の洗浄液を使うか、1カップの漂白剤と1ガロンの水を混ぜた溶液を用意する。 洗濯機で洗える衣類は、漂白剤(または漂白剤不使用の洗濯用除菌剤)を使って洗濯し、すぐに乾燥させれば、救えることもある。 未消毒のものを廃棄する 残念なことに、一度洪水被害に遭ってしまうと、十分に洗浄することがほとんど不可能な素材もある。…